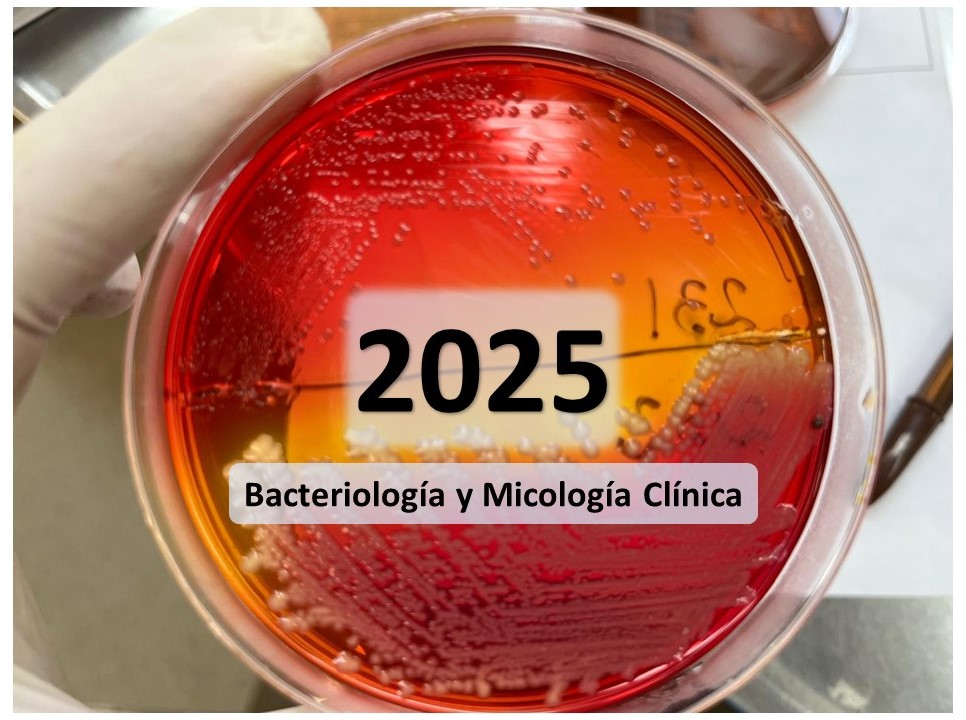

Facultad de Ciencias Exactas y Naturales y Agrimen...
Miscellaneous
Cursos de Capacitación UNNE Virtual
Diplomatura Universitaria 2019
Diplomatura 2020
DUEMT2021
DUEMT2022
DUEMT 2023
Diplomatura Superior_2023
Aulas de Práctica 2017 a 2022
Aulas de Práctica Introducción Agosto de 2020
Aulas de prácticas: Curso Prácticas e instrumentos...
Aulas de Practicas de Uso de rúbricas como instrum...
Aulas de Práctica-Introducción a la Gestión de Aul...
Capacitación para tutores ayudantes alumnos
Curso Cuestionario 2022
Taller ERAGIA2023
Congreso de Educación y Tecnologías del Mercosur
Diplomatura Universitaria en Educación Mediada por...
Nanoencuentros con las TD
DUEMT2024
Diplomatura Superior_2024
Diplomatura Superior_2025
DUEMT2025
DUEMT 2026
Diplomatura Superior_Cuarta cohorte_2026
Capacitaciones 2026
Cursos de Posgrado
Cursos de Posgrado 2025
Cursos de Posgrado 2025
Facultad de Artes, Diseño y Ciencias de la Cultura
Diplomaturas
Diplomaturas 2025
Diplomaturas 2026
Licenciatura en Artes Combinadas
2022 - LAC
2023 - LAC
2024 - LAC
2025 - LAC
2026 - LAC
Licenciatura en Gestión y Desarrollo Cultural
2022 - LGyDC
2023 - LGyDC
2024 - LGyDC
2025 - LGyDC
2026 - LGyDC
Licenciatura en Turismo
2022 - LT
2023 - LT
2024 - LT
2025 - LT
2026 - LT
Tecnicatura en Turismo
2022 - TT
2023 - TT
2024 - TT
2025 - TT
2026 - TT
Tecnicatura en Diseño de Imagen, Sonido y Multimedia
2022 - TDISyM
2023 - TDISyM
2024 - TDISyM
2025 - TDISyM
2026 - TDISyM
Cursos de capacitación
Capacitación 2024
Capacitación 2025
Capacitación 2026
Posgrado
Posgrado 2024
Posgrado 2023
Posgrado 2025
Posgrado 2026
Ingresantes FADICC
Facultad de Ciencias Económicas
Carreras de Grado
Contador Público
2022 - CP
2023 - CP
2024 - CP
2025 - CP
2026 - CP
Licenciatura en Administración
2022 - LA
2023 - LA
2024 - LA
2025 - LA
2026 - LA
Licenciatura en Economía
2022 - LE
2023 - LE
2024 - LE
2025 - LE
2026 - LE
Licenciatura en Comercio Exterior
2022 - LCE
2023 - LCE
2024 - LCE
2025 - LCE
2026 - LCE
Licenciatura en Relaciones Laborales
2022 - LRL
2023 - LRL
2024 - LRL
2025 - LRL
2026 - LRL
Materias comunes de las carreras Administración, C...
2022 - MC_ACPy E
2023 - MC_ACPy E
2024 - MC_ACPy E
2025 - MC_ACPy E
2026 - MC_ACPy E
Tecnicatura en Administración y Gestión de Institu...
Licenciatura en administración pública - Ciclo de...
Programa de Ambientación Universitaria
Secretaría Académica
SEC. ACAD 2025
SEC. ACAD 2026
Secretaría de Asuntos Estudiantiles
SEC.AS.EST. 2025
SEC.AS.EST. 2026
Secretaría de Investigación, Innovación y Desarrollo
SEC.IID - 2025
SEC.IID - 2026
Secretaría de Posgrado
Carreras de posgrado
Carreras de Posgrado 2025
Especializaciones 2025
Especializaciones 2025
Maestría en Marketing - 2º edición
Maestría en Marketing 3º Edición
Diplomatura Superior en Estudios de Procesos Socio...
Especializaciones
SEC.POSG - 2025
SEC.POSG - 2026
Secretaría de Extensión y Ejercicio Profesional
2022 - SEyEP
Diplomatura Universitaria en Gestión y Desarrollo ...
Diplomatura Universitaria en Gestión y Desarrollo ...
Diplomatura Universitaria en Gestión y Desarrollo ...
Aulas de Practicas de Evaluación con Rúbrica en Mo...
Aulas de Prácticas de Evaluación con Cuestionarios...
Diplomatura en Docencia de las Ciencias Económicas...
2023 - SEyEP
2024 - SEyEP
2025 - SEyEP
2026 - SEyEP
Facultad de Arquitectura y Urbanismo
Carrera de Diseño Gráfico
2023 - DG
2022 - DG
2024 - DG
2025 - DG
2026 - DG
Carrera Lic. en Diseño Industrial
Carrera de Arquitectura
Posgrado
Exámenes Finales
Diplomatura Superior en Arquitectura Solar
Maestría en Arquitectura Ambientalmente Responsable
Especialización en Higiene y Seguridad en el Trabajo
Cursos Posgrados 2025
Cursos Posgrados 2026
Exámenes Finales 2026
Exámenes Finales 2025
Exámenes Finales 2024
Exámenes Finales 2023
CEDIA
Materias Comunes a varias Carreras
Facultad de Ciencias Veterinarias
Facultad de Humanidades
Carreras de grado
Tecnicatura Universitaria en Tecnologías de la Inf...
Carrera de Articulación - Licenciatura en Letras
Licenciatura en Ciencias de la Información
2022 - LCI
2023 - LCI
2024 - LCI
2025 - LCI
2026 - LCI
Licenciatura en Ciencias de la Información - Sede ...
Lic./ Prof. en Letras
2022 - L/PL
2023 - L/PL
2024 - L/PL
2025 - L/PL
2026 - L/PL
Lic./ Prof. en Ciencias de la Educación
2022 - L/P CE
Profesorado en Ciencias de la Educación - General ...
Didáctica
Educación a Distancia - Práctica 2022
Educación a Distancia - Práctica 2023
2023 - L/P CE
2024 - L/P CE
2025 - L/P CE
2026 - L/P CE
Lic./ Prof. en Educación Inicial
2022 - L/P EI
2023 - L/P EI
2024 - L/P EI
2025 - L/P EI
2026 - L/P EI
Lic./ Prof. en Geografía
2022 - L/P G
2023 - L/P G
2024 - L/P G
2025 - L/P G
2026 - L/P G
Lic./ Prof. en Historia
2022 - L/P H
2023 - L/P H
2024 - L/P H
2025 - L/P H
2026 - L/P H
Lic./ Prof. en Filosofía
2022 - L/P F
2023 - L/P F
2024 - L/P F
2025 - L/P F
2026 - L/P F
Licenciatura en Comunicación Social
2022 - LCS
2023 - LCS
2024 - LCS
2025 - LCS
2026 - LCS
Mesas de exámenes
Ciencias de la Información - Exámenes
Letras - Exámenes
Educ Inicial - Exámenes
Cs de la Educación - Exámenes
Comunicación Social - Exámenes
Geografía - Exámenes
Historia - Exámenes
Filosofía - Exámenes
Lenguas extranjeras - Exámenes
Ingresantes
2022 - Ingresantes
2023 - Ingresantes
2024 - Ingresantes
2025 - Ingresantes
2026 - Ingresantes
Materias comunes a varias carreras
Profesorado en Tecnología de la Comunicación: Info...
Plan de Acompañamiento a la Culminación del Trayec...
Posgrado
Profesorado de Educación Superior
Cohorte - MP - 2019
Cohorte - MP - 2020
Cohorte - MP - 2022
Cohorte - MP - 2024
Profesorado en Educación Superior - MD - 2021
Didáctica y Curriculum de la Educación Superior
Investigación Educativa
Taller: Escritura Académica
Grupos de Enseñanza e Instituciones
Ética profesional
Historia de la Educación Superior
Los Sujetos de la Educación Superior
Política, Organización y Gestión de la Educación S...
Seminario de Análisis de la Enseñanza
Categorías 2C
Comisión 1
Comisión 2
Comisión 3
Comisión 4
Comisión 5
Comisión 6
Comisión 7
Comisión 8
Comisión 9
Comisión 10
Comisión 11
Comisión 12
Comisión 13
Aulas Módelos
Taller de Práctica de la Formación en la Disciplin...
Comisión 7
PROFESORADO EN EDUCACIÓN SUPERIOR - MD - 2 cohorte.
Profesorado en Educación Superior 2024 - Sta Lucia -
Tercera Cohorte del Profesorado en Educación Super...
Profesorados Universitarios
Carrera de Complementación Pedagógica: Profesorado...
Ciclo de Complementación Profesorado Universitario...
2018 - PU - Modalidad Virtual
2020 - PU- 5ta Cohorte - Sede Resistencia
2020 - PU - 3° - Modalidad Virtual
PUV_3°_2020_Aulas Modelo
PUV_3°_2020_Módulo 0
PUV_3°_2020_Seminario de Análisis Socio-político d...
PUV_3°_2020_Cognición y Aprendizaje en el Contexto...
PUV_3°_2020_Didáctica General
PUV_3°_2020_Taller de Integración I
PUV_3°_2020_Pedagogía Crítica y de la Formación
PUV_3°_2020_Taller de Competencias Comunicativas
PUV_3°_2020_Seminario de Educación y Diversidad
PUV_3°_2020_Educación 2.0
PUV_3°_2020_Seminario de Deontología Profesional
PUV_3°_2020_Didáctica Específica y Residencia Docente
PUV_3°_2020_Taller de Integración II
2022 - PU - 4° - Modalidad Virtual
PUV_4C_2022_Aulas Modelo
PUV_4C_2022_Módulo 0
PUV_4C_2022_Seminario de Análisis Socio-político d...
PUV_4C_2022_Cognición y Aprendizaje en el Contexto...
PUV_4C_2022_Didáctica General
PUV_4C_2022_Taller de Competencias Comunicativas
PUV_4C_2022_Taller de Integración I
PUV_4C_2022_Educación 2.0
PUV_4C_2022_Didáctica Específica
PUV_4C_2022_Residencia Docente
PUV_4C_2022_Seminario de Deontología Profesional
PUV_4C_2022_Pedagogía Crítica y de la Formación
PUV_4C_2022_Seminario de Educación y Diversidad
PUV_4C_2022_Taller de Integración II
2022 - PU - 5º - Modalidad Virtual
PUV_5C_2022_Aulas Modelo
PUV_5C_2022_Módulo 0
PUV_5C_2022_Seminario de Análisis Socio-político d...
PUV_5C_2022_Cognición y Aprendizaje en el Contexto...
PUV_5C_2022_Didáctica General
PUV_5C_2022_Taller de Competencias Comunicativas
PUV_5C_2022_Taller de Integración I
PUV_5C_2022_Didáctica Específica
PUV_5C_2022_Residencia Docente
2024 - PU - 5° - Modalidad Virtual
PUV_5C_2024_Aulas Modelo
PUV_5C_2024_Módulo 0
PUV_5C_2024_Seminario de Análisis Socio-político d...
PUV_5C_2024_Cognición y Aprendizaje en el Contexto...
PUV_5C_2024_Didáctica General
PUV_5C_2024_Taller de Competencias Comunicativas
PUV_5C_2024_Taller de Integración I
PUV_5C_2024_Pedagogía Crítica y de la Formación
PUV_5C_2024_Didáctica Específica
PUV_5C_2024_Residencia Docente
PUV_5C_2024_Educación 2.0
PUV_5C_2024_Seminario de Deontología Profesional
PUV_5C_2024_Seminario de Educación y Diversidad
PUV_5C_2024_Taller de Integración II
2026 - PU - 6° - Modalidad Virtual
Programa de Formación Académica para Estudiantes
Proyectos de Investigación
Proyectos Académicos
Capacitaciones
Extensión
Capacitación Humanidades - ACDP
Aulas_Prácticas - 2018
Diplomatura en Diseño y Gestión de tutorías
De Santos, altares y custodios.
Ext. - 2024
Ext. - 2025
Ext. - 2026
Facultad de Ingeniería
Tecnicatura Universitaria en Informática
TUI - Año 2023
TUI - Año 2022
TUI - Comisión 1
TUI - Comisión 2
TUI - Comisión 3
TUI - Año 2024
TUI - Año 2025
TUI - Año 2026
Licenciatura en Gestión Ambiental
Ingeniería Civil
2022 - IC
2023 - IC
2024 - IC
2025 - IC
2026 - IC
Ingeniería Mecánica
2022 - IM
2023 - IM
2024 - IM
2025 - IM
2026 - IM
Ingeniería Electromecánica
2022 - IE
2023 - IE
2024 - IE
2025 - IE
2026 - IE
Posgrado
Maestría en Ciencias de la Ingeniería - Virtual
Maestría en Ciencias de la Ingeniería - Presencial
ESPECIALIDAD EN GERENCIAMIENTO DE EMPRESAS CONSTRU...
ESPECIALIZACIÓN EN CONSTRUCCIÓN SUSTENTABLE
Diplomaturas Fac. Ing.
TECNICATURA UNIVERSITARIA EN INSTALACIONES ELECTRICAS
Extensión
Instituto de Ciencias Criminalísticas y Criminología
Licenciatura en Cs Criminalísticas y Criminología
2022 - LCCyC
2023 - LCCyC
Mesa de Exámenes
2023 - Crimi -Exámenes
2022 - Crimi -Exámenes
2024 - Crimi -Exámenes
2026 - Crimi -Exámenes
2024 - LCCyC
2025 - LCCyC
2026 - LCCyC
Licenciatura en Seguridad Pública y Ciudadana
2023 - LSPyC
2024 - LSPyC
2025 - LSPyC
2026 - LSPyC
Posgrados
Posgrados 2022
Posgrados 2023
Posgrados 2024
Posgrados 2025
Posgrados 2026
Cursos de formación docente
Año 2023
Año 2024
Año 2025
Año 2026
Extensión
Instituto de Medicina Regional
Facultad de Odontología
Facultad de Ciencias Agrarias
Tecnicatura Universitaria en Apicultura
Ingeniería Agronómica
2022 - IA
2023 - IA
2024 - IA
2025 - IA
Ingeniería Industrial
2022- I I
2023 - I I
2024 - I I
2025 - I I
2026 - I I
Posgrados
Tecnicatura Universitaria Foresto Industrial
Tecnicatura Universitaria en Mecanización Agrícola
Facultad de Derecho y Ciencias Sociales y Políticas
Rectorado
Programa de Formación Docente Continua
Programa de Formación a Personal No Docente
Secretaría General Académica
Programa Nexos - Formación de Docentes Tutores
Programa Nexos - Capacitación en Evaluación
Coordinación Escuelas Secundarias Técnicas
Diplomatura Superior en Evaluación de la Calidad U...
Trayectos Formativos Comunes de la carreras de Ing...
EXT. A Santo Tomé
EXT. A Goya
EXT. A Ituzaingó
EXT. A Monte Caseros
Diplomatura Superior Formación de Jurados y Comisi...
Diplomatura Universitaria: Formación de árbitros y...
UNNE - Virtual
Posgrado
Proyecto Sigamos estudiando
Programa de Articulación con otros niveles 2023
Dirección TIC
UNNE Digital - Primera Edición
UNNE Digital - Segunda Edición
UNNE Digital - Tercera Edición
Área de TI Administrativa
Secretaría General de Relaciones Interinstitucionales
Escuela de Gobernanza y Liderazgo
Secretaría General de Extensión Universitaria
EUDENE
Programa de Formación en Educación Superior Mediad...
AUGM
UNNE - Libres de violencias y discriminación
Secretaría General de Posgrado
Programa Pueblos Indígenas
SIED - UNNE
SEDE CASTELLI
Escuelas Preuniversitarias
CENTRO de ESTUDIOS SOCIALES
Escuela de Educación Profesional
EEP - Año 2025
EEP - Año 2023